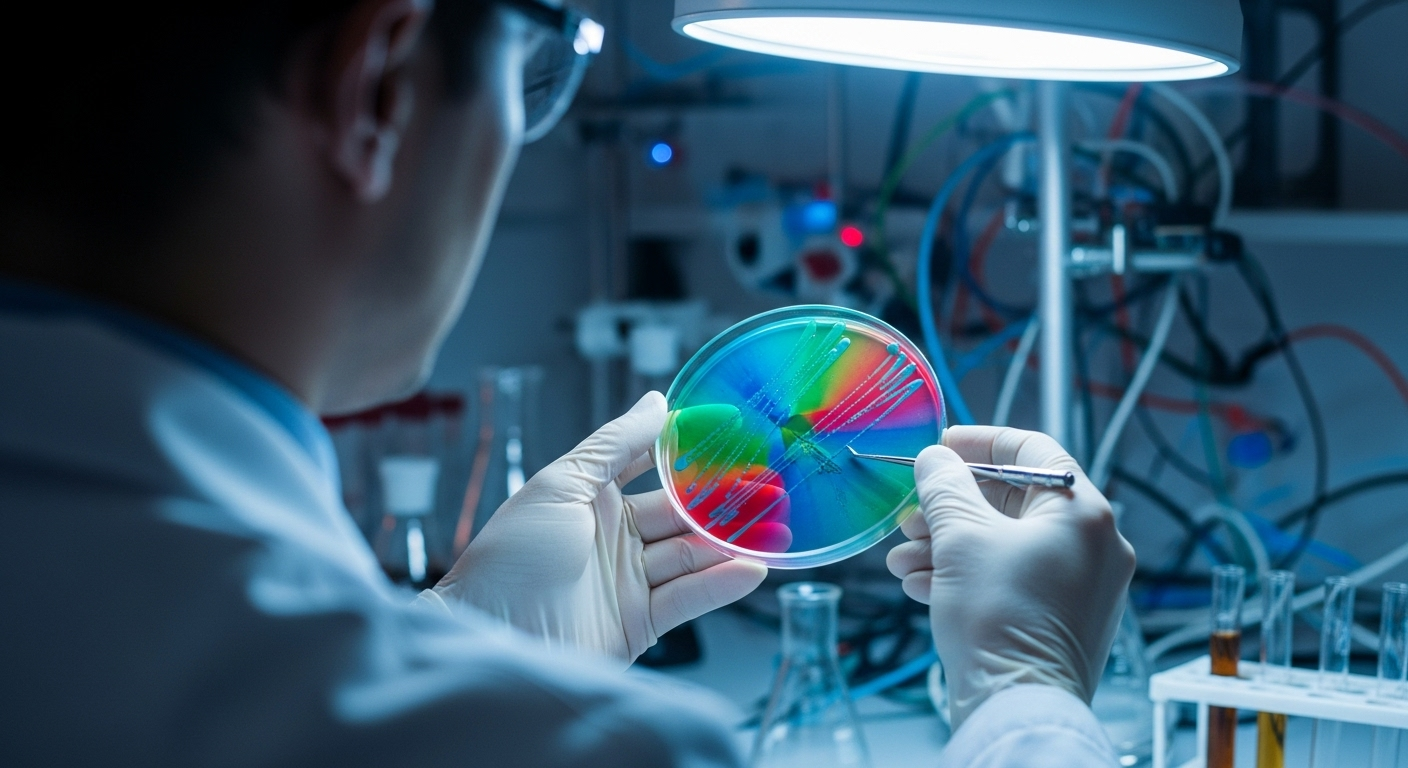
Comment les autorités ont-elles fait le lien ?

9 hospitalisations et des dizaines de malades dans une épidémie de salmonelle liée aux pistaches
Auteur: Mathieu Gagnon
On pense souvent qu’un petit plaisir comme grignoter des pistaches est sans danger. Pourtant, une récente nouvelle vient nous rappeler d’être prudents. Une éclosion de salmonelle, une bactérie qui peut nous rendre bien malades, a été liée à la consommation de pistaches de certaines marques. Le bilan est déjà sérieux : neuf personnes ont dû être hospitalisées et des dizaines d’autres sont tombées malades. Il est donc très important de bien vérifier ce que vous avez dans vos placards.
Quelles sont les marques à surveiller de près ?

Les autorités sanitaires ont été très claires. Des avertissements de rappel ont été lancés pour des produits de trois marques spécifiques. Si vous avez acheté des produits récemment, prenez le temps de vérifier s’ils appartiennent à l’une de ces marques : Habibi, Al Mokhtar Food Centre et Dubai. Le rappel ne concerne pas seulement les pistaches en sachet, mais aussi des produits qui en contiennent. Soyez donc doublement vigilants.
Où les cas ont-ils été signalés ?

Cette situation touche plusieurs régions du Canada, mais certaines sont plus affectées que d’autres. L’Agence de la santé publique du Canada a confirmé 52 cas de salmonellose, c’est-à-dire de maladie causée par la salmonelle, répartis dans quatre provinces. Le Québec est la province la plus touchée avec 39 cas. Viennent ensuite l’Ontario avec neuf cas, la Colombie-Britannique avec trois cas, et enfin le Manitoba avec un seul cas. Ces chiffres nous montrent que le problème est bien réel et s’est propagé entre le début du mois de mars et la mi-juillet.
Le chocolat populaire qui est maintenant dans la tourmente

Parmi les produits rappelés, il y en a un qui a beaucoup fait parler de lui, surtout sur internet. Il s’agit d’une tablette de chocolat au lait de la marque Dubai, fourrée avec une crème de pistache et des morceaux croquants de ‘knafeh’ (une sorte de pâtisserie fine et croustillante). Ce mélange gourmand a connu un grand succès en ligne, avec de nombreuses personnes vantant son goût unique. Malheureusement, ce chocolat fait maintenant partie des produits à ne surtout pas consommer. Il a été vendu au Québec, mais on pouvait aussi le commander en ligne, ce qui a pu contribuer à sa diffusion.
Comment les autorités ont-elles fait le lien ?
On peut se demander comment on a su que c’étaient les pistaches. L’enquête de l’Agence de la santé publique du Canada a permis de trouver la preuve. Des analyses en laboratoire ont confirmé que la souche de salmonelle qui a rendu les gens malades a été retrouvée dans des échantillons de pistaches de la marque Habibi qui avaient été rappelées.
Mais attention, l’enquête n’est pas terminée. Il est possible que d’autres aliments soient identifiés comme source de contamination. Surtout, les autorités nous préviennent que le nombre de 52 cas est probablement bien inférieur à la réalité. Beaucoup de gens qui ont des symptômes légers ne vont pas chez le médecin et ne sont donc pas comptabilisés.
Conclusion : qu'est-ce que la salmonelle et comment s'en protéger ?

La salmonelle est une bactérie que l’on trouve dans les aliments contaminés. Elle peut provoquer une infection qui se déclare plusieurs jours, voire semaines, après avoir mangé le produit. Même si on ne se sent pas malade, on peut quand même la transmettre.
Pour une personne en bonne santé, les symptômes sont souvent de courte durée : fièvre, maux de tête, vomissements, nausées, crampes et diarrhée. Mais il faut être très prudent, car pour les personnes plus fragiles comme les enfants, les femmes enceintes, les personnes âgées et celles dont le système immunitaire est affaibli, l’infection peut être beaucoup plus grave, et même mortelle. La meilleure chose à faire est de jeter les produits concernés et de bien se laver les mains. En cas de doute ou si vous ressentez ces symptômes, n’hésitez pas à consulter votre médecin.
Selon la source : thecanadianpressnews.ca










